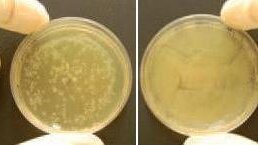
Prozone potwierdza skuteczność ozonu w leczeniu stomatologicznym

Badania kliniczne przeprowadzone w Zakładzie Biologii Molekularnej Uniwersytetu w Salzburgu (Austria) potwierdziły, że leczenie stomatologiczne z wykorzystaniem urządzenia Prozone – generatora ozonu nowej generacji austriackiej firmy W&H, skutecznie działa na szczepy bakterii odpowiedzialnych za infekcje jamy ustnej i rozwój próchnicy zębów.
W ramach badania kontrolnego, przeprowadzonego w 2009 r. próbki Streptococcus mutans i Escherichia coli kilkakrotnie poddawano działaniu ozonu przez okres 24 s, stosując go natychmiast lub po 1,5 godz. Wyniki wskazują, że działanie ozonem przez 24 s wywierało widoczny efekt w obszarze jego zastosowania. We wszystkich przeprowadzonych badaniach leczenie natychmiastowe było bardziej skuteczne niż leczenie po upływie 1,5 godz. Po wydłużeniu czasu działania ozonu uzyskiwano także zwiększenie obszaru wolnego od bakterii lub zasiedlonego przez nieliczne bakterie.
Zastosowanie ozonu – reaktywnej trójatomowej cząsteczki tlenu, występującej także w atmosferze ziemskiej to stosunkowo nowy pomysł w stomatologii. Wcześniejsze badania wykazują, że wystarczy kilkusekundowa aplikacja, aby zabić 99% bakterii. Jest to więc metoda 1.000 razy bardziej skuteczna niż stosowanie innych środków bakteriobójczych. Nowe badanie wykazało, że dla osiągnięcia najlepszych efektów leczenie powinno zostać przeprowadzone tak szybko, jak to możliwe. Choć opóźnione leczenie także prowadziło do zmniejszenia liczby bakterii, to widoczne efekty nie były już tak spektakularne.
Urządzenia takie jak Prozone, emitujące ozon poddają przefiltrowane powietrze działaniu wysokonapięciowych wyładowań. Uzyskany gaz jest aplikowany bezpośrednio na pole zabiegowe, gdzie prowadzi do niszczenia bakterii i wirusów poprzez reakcje utleniania.
Z komunikatu opublikowanego 9 października br. na łamach „Journal of Public Health Dentistry” wynika, że amerykańscy chirurdzy szczękowo-twarzowi w...
Według badań pewne cechy mogą definiować rodzaj obturacyjnego bezdechu sennego (OBS), który można skutecznie leczyć za pomocą specjalnego ...
Kalifornijscy naukowcy pracują nad małym, ale potężnym sojusznikiem, który może pomóc w zapobieganiu infekcjom po leczeniu kanałowym. W badaniu ...
Badania wykazały, że próchnica zębów jest najczęstszą i najbardziej kosztowną chorobą jamy ustnej wywoływaną przez biofilm. Fluor jako główny ...
Polski ustawodawca uregulował odpowiedzialność lekarza oraz lekarza dentysty, w tym odpowiedzialność na gruncie prawa karnego, za błędy popełniane ...
W nowym badaniu naukowcy z Uniwersytetu L'Aquila we Włoszech podkreślili znaczenie stanu zdrowia jamy ustnej dla pacjentów z nadciśnieniem. Wnioski z ...
„Sprawienie bólu pacjentowi podczas leczenia nie jest jednorazowym problemem. Nawet incydent może pozostawić w psychice uraz, który przez lata będzie...
Pacjenci przyjmujący leki z grupy bisfosfonianów stanowią grupę ryzyka wystąpienia martwicy kości BRONJ. Przy właściwym postępowaniu można ...
Kontrola płytki stanowi podstawę profilaktyki i kontroli chorób przyzębia oraz próchnicy. Mimo że przepływ śliny powoduje w ...
Na całym świecie ok. 34 mln ludzi żyje z HIV/AIDS. 2,5 mln nowych osób co roku zaraża się wirusem HIV. Wg szacunków Centers for Disease ...
Webinarium na żywo
czw. 4 czerwca 2026
8:00 (CET) Warsaw
Webinarium na żywo
pon. 8 czerwca 2026
6:00 (CET) Warsaw
Webinarium na żywo
pon. 8 czerwca 2026
7:00 (CET) Warsaw
Dr. Anthony Mak B.D.S, Prof. Marleen Peumans
Webinarium na żywo
pon. 8 czerwca 2026
8:00 (CET) Warsaw
Webinarium na żywo
śro. 10 czerwca 2026
5:00 (CET) Warsaw
Webinarium na żywo
śro. 10 czerwca 2026
8:00 (CET) Warsaw
Nacho Fernández-Baca DDS, MSc
Webinarium na żywo
czw. 11 czerwca 2026
1:00 (CET) Warsaw



 Austria / Österreich
Austria / Österreich
 Bośnia i Hercegowina / Босна и Херцеговина
Bośnia i Hercegowina / Босна и Херцеговина
 Bułgaria / България
Bułgaria / България
 Chorwacja / Hrvatska
Chorwacja / Hrvatska
 Czechy i Słowacja / Česká republika & Slovensko
Czechy i Słowacja / Česká republika & Slovensko
 Francja / France
Francja / France
 Niemcy / Deutschland
Niemcy / Deutschland
 Grecja / ΕΛΛΑΔΑ
Grecja / ΕΛΛΑΔΑ
 Węgry / Hungary
Węgry / Hungary
 Włochy / Italia
Włochy / Italia
 Holandia / Nederland
Holandia / Nederland
 nordycki / Nordic
nordycki / Nordic
 Polska / Polska
Polska / Polska
 Portugalia / Portugal
Portugalia / Portugal
 Rumunia i Mołdawia / România & Moldova
Rumunia i Mołdawia / România & Moldova
 Słowenia / Slovenija
Słowenia / Slovenija
 Serbia i Czarnogóra / Србија и Црна Гора
Serbia i Czarnogóra / Србија и Црна Гора
 Hiszpania / España
Hiszpania / España
 Szwajcaria / Schweiz
Szwajcaria / Schweiz
 indyk / Türkiye
indyk / Türkiye
 Wielka Brytania i Irlandia / UK & Ireland
Wielka Brytania i Irlandia / UK & Ireland
 Międzynarodowy / International
Międzynarodowy / International
 Brazylia / Brasil
Brazylia / Brasil
 Kanada / Canada
Kanada / Canada
 Ameryka Łacińska / Latinoamérica
Ameryka Łacińska / Latinoamérica
 USA / USA
USA / USA
 Chiny / 中国
Chiny / 中国
 Indie / भारत गणराज्य
Indie / भारत गणराज्य
 Pakistan / Pākistān
Pakistan / Pākistān
 Wietnam / Việt Nam
Wietnam / Việt Nam
 ASEAN / ASEAN
ASEAN / ASEAN
 Izrael / מְדִינַת יִשְׂרָאֵל
Izrael / מְדִינַת יִשְׂרָאֵל
 Algieria, Maroko i Tunezja / الجزائر والمغرب وتونس
Algieria, Maroko i Tunezja / الجزائر والمغرب وتونس
 Bliski Wschód / Middle East
Bliski Wschód / Middle East

To post a reply please login or register